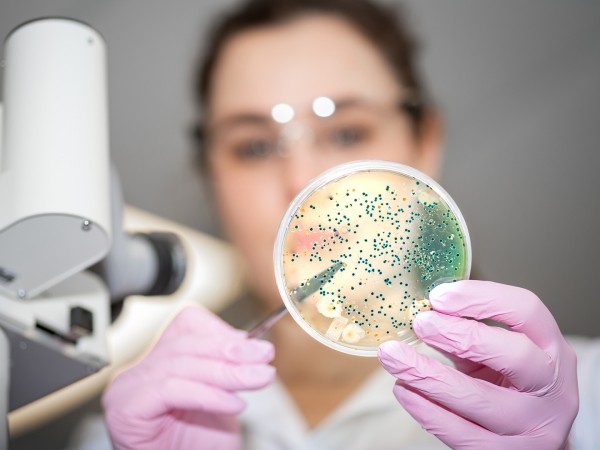
Исследователи выяснили, что жизнь после смерти есть, но в рай вы не попадете Исследователи выяснили, что жизнь после смерти есть, но в рай вы не попадете

Исследователи выяснили, что жизнь после смерти есть, но в рай вы не попадете
Смерть, эта загадочная и неизбежная часть жизни, всегда была и остается одним из наиболее волнующих вопросов для человечества. Существуют различные теории о том, что нас ожидает после этой необратимой грани, однако, кажется, что ученые университета Теннесси нашли ответ в самом неожиданном месте: внутри нас самих. Так есть ли жизнь после смерти?
Есть ли жизнь после смерти, но в рай вы не попадете
Многие считают, что смерть — это окончательная точка, после которой наше существование прекращается полностью. Однако, исследование, проведенное микробиологами из университета Теннесси, показало, что часть нашего организма продолжает свое существование даже после нашей физической гибели. Речь идет о микробиоме кишечника — удивительной вселенной микроорганизмов, населяющих наше пищеварительное тракт, передает сайт Rsute.ru.
Микробиом кишечника считается одним из самых сложных и важных «органов» в нашем организме. Он состоит из более чем 100 триллионов микроорганизмов, и его общая масса составляет от 2 до 3 килограммов. Исследования показали, что эти микробы, или некробиомы, как их называют, способны выживать даже после того, как тело перестало функционировать.

Что делает этот феномен еще более захватывающим, так это то, что эти микробы могут существовать без кислорода и питаться тканями нашего организма, активно стимулируя его разложение. Хотя это может показаться несколько ужасающим, это также является своего рода подтверждением жизни после смерти.
Профессор экологической микробиологии, Дженнифер ДеБрюн, отмечает, что это открытие представляет собой «микроскопическое доказательство нашей жизни после смерти». Микробиологи объясняют, что это явление имеет важное значение с эволюционной точки зрения. Эти микробы адаптировались к тому, что человек умирает, и готовы после его смерти искать новые «дома» для колонизации. Обычно этим «домом» становится почва, и именно поэтому около кладбищ и мест, где похоронены животные, заметно больше зелени.
Комментарии закрыты.